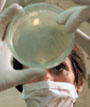

МОСКВА, 18 ОКТЯБРЯ
ЖИЗНЬ | СМЕРТЬ
в конверте

Софья Игнатьевна, привет!
Надеюсь, вы живы-здоровы. У меня к вам предложение. Не напишете ли вы мне подробное, но вполне человеческое письмо о том, как там обычные люди переживают события, в частности панику по поводу язвы? Хотелось бы, чтобы это письмо было веселым и жизнеутверждающим, а пришло ко мне где-нибудь в понедельник-вторник. Если мое предложение повергло вас в шок или недоумение, простите великодушно.
Пока. Боря Минаев.
DENVER, COLORADO, 20 ОКТЯБРЯ

Привет!
Ну вот, я вернулась в Колорадо. Тут все еще теплынь, только снежные шапки на горах распушились и спустились пониже: не шапки уже — палантины! У нас ведь снег выпадает как снег на голову, минуя осень, прямо посередь лета. О своем появлении предупреждает свистом в трубе и сводкой погоды по телевизору. Пока не посмотришь на экран, не веришь, что этому безоблачному (в прямом смысле слова) великолепию может наступить конец.
Пока не смотришь на экран...

В Денвер утро приходит на два часа позднее, чем в Нью-Йорк. Когда 11 сентября мы включили ТВ, там все уже произошло. Мы увидели кадры, которые показались омерзительно знакомыми: нечто похожее мелькало в фантастических фильмах, которые я терпеть не могу и потому никогда толком не смотрела. Не они ли, любители творить ужасы «понарошку», подсказали сюжет творцам ужасов наяву? Поверить в эти, реальные, было так же выше сил, как в те, выдуманные. Общее ощущение сводилось к: «Не могу вместить». Однако вместить пришлось и начать следовало с проверки: кто где? Спасибо Елене Боннэр: с присущей ей четкой деловитостью прислала e-mail: «Все родные, друзья живы». Целый круг знакомых, близких и не очень близких, можно было вычеркнуть из страшного списка. Когда звонила по нью-йоркским номерам, всплыл полувековой давности страх: ждать отклика от того, кого, быть может, нет на свете, — аукнулось военное детство.
И еще Елена Боннэр писала, что мир изменился.
Как изменился, увидали мы в аэропорту. Мы им жутко гордимся, нашим аэропортом какого-то там сверхнового поколения. Тут тебе и зимние сады, и фонтаны, и портреты индейцев различных племен, и куча нарядных лавчонок, кафе, ресторанчиков... Даже метро есть, единственное в городе. Так вот, из цветущего сада наш аэропорт превратился в осажденную крепость: всех обыскивают, провожающих не впускают, сумки потрошат, а чтобы успеть распотрошить каждого, велят являться за четыре часа до рейса. В моем случае — к семи утра.
Фонтаны прилежно били, цветы и ветви декоративно свисали, кафе и магазины своевременно открывались — и все это было ни для кого. Никто не смотрел в их сторону. Некому было. В просторных тщательно надраенных вестибюлях змеились две унылые очереди, оцепленные полицейскими: пассажиры ждали проверки. Чтобы подбодрить, каждые четверть часа перед тобой вырастал плакат: «Ура! Осталось меньше половины!» или «Не теряй терпения: осталось 10 минут!» Ума не приложу, как это они сумели рассчитать так точно? В самом деле, плакат, обещавший десять минут, не соврал: ровно через десять минут чернокожая матрона в форме ловко извлекла из моей дорожной сумки крошечные маникюрные ножницы: «Для вашей безопасности, мэм». Я подумала, что, ежели жить без ножниц, можно отрастить такие когти, что еще будут поопаснее, но поостереглась высказать свои соображения вслух: глядишь, еще и ногти конфискуют.
Не знаю, что привело в аэропорт тех, кто вместе со мною томился в очередях, а потом ехал в почти пустом вагоне метро, но могу себе представить, как бы они изумились, узнав, куда направляюсь я. Я сама в это с трудом верила. После 11 сентября казалось естественным, что конференцию, посвященную наследию Осипа Мандельштама и приуроченную к 25-летию передачи его архива в Принстонский университет, в Принстоне проводить не станут. В такое время, да еще так близко от Нью-Йорка. И что никто в такое время в такое место не поедет.

Однако конференция в назначенный день и час открылась, все, кого ждали, появились, публика заполнила обширный зал, журналисты заняли свои места — и все, что не имело отношения к поэзии, отступило на задний план.
Конференция планировалась в мирное время, и я тогда пообещала бывшей моей американской аспирантке, а теперь подруге, которая живет в полутора часах езды от Принстона, непременно ее навестить в ее новом доме. Эдакое задумывалось увеселительное путешествие для меня и развлечение для нее. В штат Пенсильвания Дафни переехала не так давно, а до того жила в Нью-Йорке и работала в одной из тех башен, то на 102-м этаже, то чуть выше или чуть ниже. Помню, как рассказывала, что никогда не знает, какая погода на улице: у них над облаками сияло солнце, а внизу мог идти дождь. Там, на 102-м, чуть ниже, чуть выше, остались ее друзья. Когда я спросила о них, она ответила сдержанно: «Их ищут». Потом столь же сдержанно сообщила, что дважды на прошлой неделе ездила в Нью-Йорк на панихиды.

Она встретила меня — красивая, приветливая, элегантная. Уделила мне массу времени и внимания, стараясь сделать мое пребывание у нее приятным. О происшедшем отозвалась так:
«Мы слишком верили в добро. Мы старались быть доброй силой в мире и думали, что весь мир любит нас. Вот в чем наша ошибка».
Показывая свой ухоженный, нарядный сад, отметила уголок:
«Здесь будет просвещенный... Нет, — она помолчала, вспоминая русское слово, — посвященный сад. Памяти Майкла. Тут будут розы. Он любил розы».

На пути к ней, затем по дороге в Филадельфию и на обратном пути в один из нью-йоркских аэропортов мне пришлось трижды проезжать городок под названием Трентон и делать там пересадку. В те самые дни оттуда были посланы смертоносные депеши, содержащие споры сибирской язвы. Такой симпатичный чистенький городок, вполне мирного вида...
Теперь под безоблачным колорадским небом я могу наблюдать, как мои соседки, натянув маски, распечатывают почту на улице, внутри пластиковых мешков. И добродушно посмеиваются над собой, обнаружив в подозрительном конверте очередную рекламу.
В сорок четвертом ходила такая притча. Высокий чин из США посетил Москву лютой зимою и обратил внимание на толпы, мерзнувшие на морозе. Осведомился, что, мол, происходит. Ему объяснили: очередь за мороженым. И тогда будто бы он воскликнул: «Воистину этот народ непобедим!»
Я думаю, что народ, который, находясь под ударом невидимого вездесущего противника, считает возможным устроить и с большим размахом провести конференцию, посвященную иноязычному поэту; который держит в идеальном порядке свои обезлюдевшие аэропорты и старается шуткой смягчить неудобство и унизительность обысков; с мужественной сдержанностью поминает ушедших и не оставляет ежеминутной заботы об окружающих, — ведь такой народ свой образ жизни и свое представление о ней сломать не позволит. Как ты думаешь?
Будь здоров!
Твоя С. Б.
P.S.: Мы переписывались с московским литературоведом Софьей Игнатьевной Богатыревой по электронной почте. Именно эта почта в октябрьские дни спасла человечество от страха «смерти в конверте». Именно она помогла людям не потеряться в океане зловещего одиночества, когда ждешь белого порошка в своем почтовом ящике. Спасибо этому дурацкому изобретению за неожиданный гуманизм.
Борис МИНАЕВ
В материале использованы фотографии: Михаила СОЛОВЬЯНОВА, Reuters
